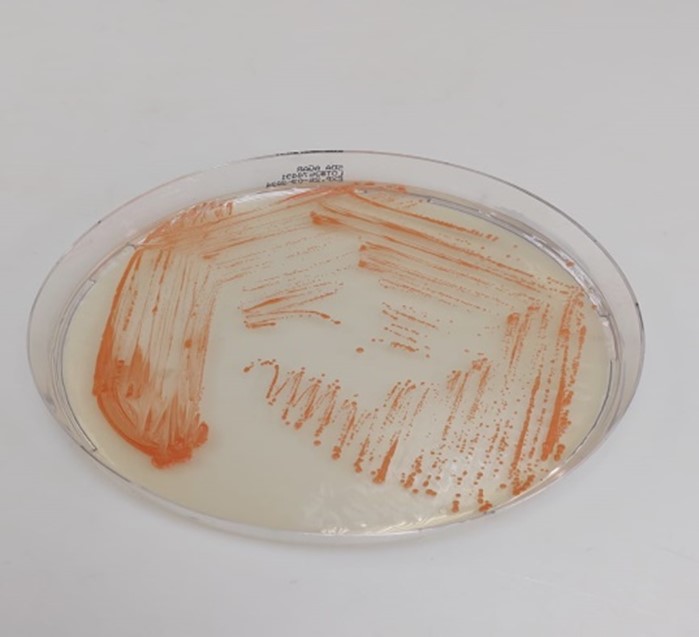

Cutaneous Rhodococcus Infection in an Immunocompetent Individual: A Case Report
Iftikhar Ahmad1,*, Salma Abbas1, Summiya Nizamuddin2, Muhammad Usman Shabbir1, Aun Raza1, Sajjad Ali1 and Faisal Sultan1
1Department of Internal Medicine & Infectious diseases, Shaukat khanum memorial cancer hospital & research center, Lahore, Pakistan
2Department of Microbiology, Shaukat khanum memorial cancer hospital & research center
Received Date: 30/12/2025; Published Date: 09/02/2026
*Corresponding author: Iftikhar Ahmad, Department of internal Medicine & Infectious diseases, Shaukat khanum memorial cancer hospital & research center, Lahore, Pakistan
Abstract
We report a rare case of cutaneous Rhodococcus infection in an immunocompetent 33-year-old male, presenting with a chronic ulcerative lesion on his right leg. Despite initial improvement with empiric antibiotics, the lesion worsened, and tissue culture eventually grew Rhodococcus species. Treatment with moxifloxacin and rifampicin, followed by azithromycin and rifampicin for a total of 6-week duration, led to complete resolution. This case highlights the rarity of Rhodococcus infection in immunocompetent individuals and its unusual presentation as skin and soft tissue infection.
Introduction
Rhodococcus species are gram-positive, aerobic bacteria that mostly infect immunocompromised individuals causing pulmonary infections in patients with HIV/AIDS, cancer, or those receiving immunosuppressive therapy [1,2]. These opportunistic pathogens can cause a wide range of infections, such as pneumonia, bacteremia, and endocarditis [3]. Cutaneous Rhodococcus infections are extremely rare, with only a few cases reported in the literature [4,5].
Rhodococcus equi is the most common specie that typically infects animals, such as horses and cattle [6]. Rhodococcus fascians and Rhodococcus erythropolis, are the other species that have been implicated in human infections [7].
Rhodococcus infections are rarely seen in immunocompetent individuals. it is often associated with history of significant trauma or exposure to contaminated soil or water [8]. Here, we report a rare case of cutaneous Rhodococcus infection in an immunocompetent 33-year-old male, presenting with a chronic ulcerative lesion on the leg.
This case highlights the importance of considering Rhodococcus species in the differential diagnosis of cutaneous infections, even in immunocompetent individuals. It also Highlights the challenges of diagnosing and managing these infections, particularly in the absence of characteristic clinical features.
Case Presentation
A 33-year-old gentleman, presented with a 6–7-week history of an ulcerative lesion on the medial aspect of his right leg (Figure 1). The lesion began as a small, tender papule that progressed over the next couple of weeks to a hard nodule with surrounding erythema, eventually opening up with purulent orange to red color discharge and developed into a nonhealing tender ulcerative lesion.

Figure 1: Wound at presentation.
There was no associated itching, fever, or systemic symptoms and he denied any insect bite and preceding trauma.
Prior evaluation by dermatologists suggested cellulitis or carbuncle, leading to treatment with multiple antibiotics including cefixime, linezolid, and amikacin for 3 weeks. Although discharge improved, the lesion remained erythematous with persistent hardness and tenderness.
The patient was non diabetic and had prior history of cutaneous infections including hidradenitis suppurativa, peri-anal abscess managed with antibiotics and a surgery for pilonidal sinus 2 years back.
His recent travel history revealed visit to Thailand and Australia in February and March 2024 respectively, where he engaged in fresh water and salt water activities.
Upon presentation at our institution in April 2024, the patient was vitally stable and afebrile. On local examination there was a well circumscribed, raised ulcerative and tender lesion on the medial aspect of his right leg about 5-6 inches above the medial malleolus measuring approximately 3x4 inches. It had an irregular surface with pitting, erythema, oozing seropurulent yellowish discharge and minimal surrounding skin hyperpigmentation. There were no systemic signs of note.
Laboratory tests, including complete blood count (CBC), renal function tests (RFT’s), liver function tests (LFT’s), hepatitis and HIV screening, were unremarkable (Table 1).
Table 1: Laboratory Investigations.

Chest X-ray was normal and X-ray of right leg had no signs of osteomyelitis. Tissue culture from the lesion site initially grew Serratia marcescens and Escherichia coli, prompting treatment with ertapenem (Figure 3). However, prolonged incubation for 2-weeks revealed salmon-pink colored smooth, mucoid colonies (Figure 2), identified as gram positive, aerobic, club-shaped catalase and urease positive Rhodococcus. Tissue biopsy from the lesion showed extensive dermal inflammation, focal keratin debris, and ruptured epidermal inclusion cyst.
Figure 2: Salmon pink colored smooth, mucoid colonies of Rhodococcus after 2-weeks of incubation.

Figure 3: Wound after using 2 weeks of Ertapenem.
He was commenced on combination therapy with moxifloxacin and rifampicin for 2 weeks (Figure 4), followed by azithromycin and rifampicin based on in vitro susceptibility for another 4 weeks, which led to complete wound resolution (Figure 5).

Figure 4: Wound after using Moxifloxacin and rifampicin for 2 weeks.

Figure 5: Wound site at the end of targeted 6-weeks of antibiotics.
Discussion
The present case report highlights a rare presentation of cutaneous Rhodococcus infection in an immunocompetent individual. Rhodococcus species typically affect immunocompromised individuals [1]. The patient's immunocompetent status and lack of underlying medical conditions make his presentation unusual.
The clinical presentation of the patient, characterized by a chronic ulcerative lesion on the leg, is consistent with previously reported cases of cutaneous Rhodococcus infection [3,4]. However, the absence of systemic symptoms and fever is noteworthy, as Rhodococcus infections often present with high grade fever, chills, and malaise [5].
The diagnostic challenges encountered in this case highlight the importance of prolonged tissue culture incubation as initial cultures grew Serratia marcescens and Escherichia coli, which led to inappropriate antibiotic therapy. The subsequent growth of Rhodococcus species after 14 days of incubation emphasizes the need for prolonged culture times when suspecting unusual pathogens [6].
The patient's travel history to Thailand, Australia and potential exposure to contaminated soil or water may have contributed to the acquisition of the infection [7]. However, the exact mode of transmission remains unclear.
The treatment regimen employed in this case, consisting of moxifloxacin and rifampicin, followed by azithromycin and rifampicin, was effective in resolving the infection. This combination therapy is consistent with recommended treatment guidelines for Rhodococcus infections [9].
Several factors may have contributed to the patient's favorable outcome, including his immunocompetent status, prompt medical attention, and appropriate antibiotic therapy. The absence of underlying medical conditions and the localized nature of the infection likely facilitated successful treatment.
This case report contributes to the limited literature on cutaneous Rhodococcus infections in immunocompetent individuals. It reflects the importance of considering rare pathogens in the differential diagnosis of cutaneous infections and necessitates the need for prolonged incubation of tissue culture.
Conclusion
The present case report highlights several key aspects of this rare and under reported infection. While dealing with chronic cutaneous infections uncommon pathogens should be considered in differential diagnosis even in immunocompetent individuals. Prolonged tissue culture incubation and special considerations may be required while diagnosing Rhodococcus infections. Tailored antibiotics therapies are required for managing Rhodococcus species. Moreover, this case expands our understanding of Rhodococcus infections beyond their typical association with immunocompromised hosts and pulmonary involvement.
References
- Topino S, Galati V, Grilli E, Petrosillo N. Rhodococcus equi infection in HIV-infected individuals: case reports and review of the literature. AIDS patient care and STDs, 2010; 24(4): 211-222.
- Muñoz P, Burillo A, Palomo J, Rodríguez-Créixems M, Bouza E. RHODOCOCCUS EQUI INFECTION IN TRANSPLANT RECIPIENTS: Case Report and Review of the Literature. Transplantation, 1998; 65(3): 449.
- Lin WV, Kruse RL, Yang K, Musher DM. Diagnosis and management of pulmonary infection due to Rhodococcus equi. Clinical Microbiology and Infection, 2019; 25(3): 310–315. https://doi.org/10.1016/j.cmi.2018.04.033.
- Kedlaya I, Ing MB, Wong SS. Rhodococcus equi Infections in Immunocompetent Hosts: Case Report and Review. Clinical Infectious Diseases, 2001; 32(3): e39–e46. https://doi.org/10.1086/318520.
- Rhodococcus infection: A 10-year retrospective analysis of clinical experience and antimicrobial susceptibility profile | Journal of Clinical Microbiology. (n.d.), 2024.
- Rhodococcus equi infection in foals: The science of ‘rattles’—MUSCATELLO - 2007—Equine Veterinary Journal—Wiley Online Library. (n.d.), 2024.
- Rhodococcus erythropolis septicaemia in a patient with acute lymphocytic leukaemia | Microbiology Society. (n.d.), 2024.
- Rhodococcus equi: An animal and human pathogen | Clinical Microbiology Reviews. (n.d.), 2024.
- Sandkovsky U, Sandkovsky G, Sordillo EM, Polsky B. Rhodococcus equi infection after reduction mammaplasty in an immunocompetent patient. Revista Do Instituto de Medicina Tropical de São Paulo, 2011; 53: 291–294.

